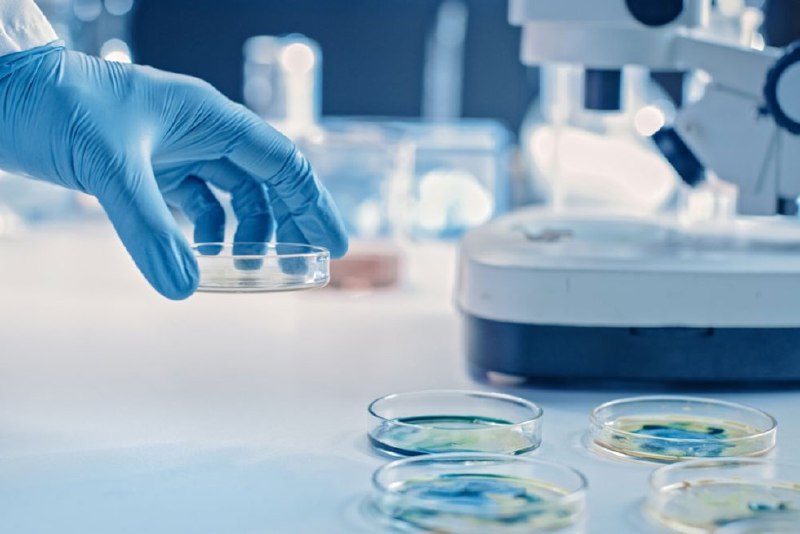

В Китае продолжается вспышка метапневмовируса, и хотя в ВОЗ считают, что угрозы новой пандемии она не представляет, эксперты отмечают рост заболеваемости и в других странах, в частности, в Великобритании.
Что представляет собой эта респираторная инфекция, как диагностируется метапневмовирус и насколько он опасен для детей, рассказал врач-инфекционист, доцент кафедры инфекционных болезней у детей Института материнства и детства Пироговского Университета Иван Коновалов.
Фото: iStock
@rgrunews
Источник: t.me
